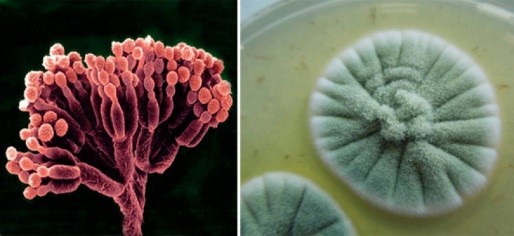

from 01.01.2022 to 01.01.2025
Saint Petersburg, St. Petersburg, Russian Federation
Saint Petersburg, St. Petersburg, Russian Federation
UDC 620.1
UDC 691.32
CSCSTI 67.01
Russian Library and Bibliographic Classification 308
This article examines a method for protecting building structures and facilities from mold biodegradation. This approach takes into account the potential of the building system itself and addresses geoecological challenges related to preserving natural mineral resources. Natural resource conservation is achieved by increasing the biostability of building structures. It has been shown that the fungicidal resistance of building systems is ensured by the porous structure of concrete and thermodynamically substantiated processes of interaction of concrete components with copper and nickel compounds. The possibility of using fungicidal compounds as a chemical additive in concrete mixture at the stage of concrete production and during operation of the finished construction project is demonstrated.
building systems, fundamental properties, thermodynamic calculations, heavy metal ions, biodestructors, fungicidal additives
Строительная отрасль сегодня остро нуждается в научном обосновании и практической реализации геоэкологических подходов на всех стадиях жизненного цикла строительных объектов, включая проектирование, строительство и эксплуатацию зданий и сооружений. Такой подход обусловлен мощнейшей индустриализацией, охватившей все страны мира, которая привела к значительному снижению продуктивности природных ресурсов и, как следствие, природно-техногенной среды. При этом, требуются не простые природозащитные мероприятия, а научный, теоретический подход к решению проблем, породивших угрозу окружающей среде. Так, геоэкоинженерные решения могут быть реализованы на основе определенных процессов, происходящих в гидросиликатных системах в виде конструкций, сооружений или их совокупности.
В научных трудах Л. Б. Сватовской и ее учеников [1-5] разработанные методы защиты природно-техногенной среды основываются на фундаментальных свойствах строительных гидросиликатных систем, к которым отнесены способность к самопроизвольному поглощению растворов различной природы за счет пористой структуры таких систем и дальнейшему взаимодействию компонентов гидросиликатной системы с поглощенными средами, термодинамическая возможность которого была определена. Если в качестве раствора выступает раствор подвижной формы тяжелого металла, являющейся токсичной для геосреды, то строительные объекты из бетона могут выступать в качестве минеральных геоантидотов, что было экспериментально доказано в работах ученых под руководством Л. Б. Сватовской [1-5]. Важно отметить, что детоксикационная способность строительных систем цементной природы имеет научное обоснование в виде термодинамического расчета, показавшего возможность самопроизвольного протекания реакции взаимодействия компонентов бетона с ионами тяжелых металлов (ИТМ) (Таблица 1), а потому детоксикация геосреды может быть осуществлена за счет собственных энергетических резервов строительной системы, без привлечения дополнительных энергозатрат извне.
Таблица 1
Термодинамический прогноз процесса взаимодействия
компонентов строительной системы с ИТМ
|
Примеры процессов взаимодействия ИТМ |
ΔG0298 процесса, кДж |
|
2CaO∙SiO2(т)+Cu2+aq+2OH-aq+1,17H2O(ж)→2CaO∙SiO2·1,17H2O(т)+Cu(OH)2(т) |
-120,56 |
|
5CaO∙6SiO2∙5,5H2O+Cu2+aq+2OH-aq+5H2O(ж)→Cu(OH)2(т)+5CaO∙6SiO2∙10,5H2O(т) |
-120,63 |
В продолжение идеи Л. Б. Сватовской об использовании термодинамически обоснованной реакции взаимодействия ИТМ с компонентами строительной системы на цементной основе в детоксикационных целях нами была определена возможность применения данной реакции при решении проблемы повреждения зданий и сооружений, находящихся в условиях биологически агрессивной среды.
В эпоху стремительного развития технологий и урбанизации вопрос обеспечения долговечности и сохранности зданий и сооружений приобретает особую актуальность. Бетон как строительный материал имеет ряд особенностей, таких как гигроскопичность, пористость, кислотонеустойчивость, что делает этот материал «привлекательным» для организмов-биодеструкторов. К биологическим агентам, вызывающим биологическую коррозию, относятся представители разных систематических групп живых существ (Рис. 1): бактерии, грибы, лишайники, водоросли, высшие растения, беспозвоночные и позвоночные животные.

Рис. 1. Многообразие биодеструкторов строительных материалов
Наиболее значимыми агентами деградации строительных конструкций являются плесневые грибы или микромицеты. Грибы (Fungi, или Mycota) — гетеротрофные организмы, источником углерода для них служат готовые органические вещества. Среди грибов значительная группа использует для питания углеродсодержащие органические соединения, которые могут входить в состав строительных материалов, например, бетона, при их модификации комплексными добавками на органической основе, например, суперпластифицирующими добавками на основе поликарбоксилатных полимеров. Кроме того, источником органических веществ могут служить различного рода загрязнения, попадающие на материалы.
Разрушение природных и искусственных каменных материалов, в том числе бетона, можно связать с жизнедеятельностью микроскопических плесневых грибов (микромицетов). Микромицеты развиваются везде, где есть минимальные условия для их существования. Высокая деструктивная активность плесневых грибов связана с их уникальной способностью адаптироваться к различным по природе материалам [6]. Основным условием, способствующим развитию плесневых грибов на бетонных конструкциях, является вода, которая выступает решающим фактором роста и накопления биомассы, а также органические вещества. В процессе своей жизнедеятельности микромицеты разрушают сформированную структуру строительного материала, что снижает его прочностные характеристики и ведет к разрушению конструкции, а также провоцируют ряд серьёзных заболеваний человека (микозы, астму, пневмонию).
Анализ литературных источников [7-9] позволяет утверждать, что разрушающее воздействие микромицетов на строительные материалы гидросиликатной природы обусловлено агрессивным влиянием метаболитов (продуктов жизнедеятельности) грибов, к которым относятся органические карбоновые кислоты и ферменты. В результате исследований [10] установлено, что для бетона агрессивной является концентрация органических кислот от 0,05 г/л.
Основное негативное воздействие на бетоны оказывают щавелевая (1) и лимонная (2) кислоты, которые разрушают гидроксид кальция, образующийся при твердении бетона в результате реакции гидратации трёхкальциевого силиката, 3CaO∙SiO2, и формирующий структуру бетона по следующим реакциям:
| C2H2O4+Ca(OH)2=CaC2O4+2H2O | (1) |
| 2C6H8O7+3Ca(OH)2=Ca3(C6H5O7)2+H2O, | (2) |
что приводит к разрушению сформированной структуры бетона.
Органические кислоты понижают pH на поверхности бетона или других строительных материалов, повышая, таким образом, агрессивность среды и стимулируя процессы биодеструкции. Кроме того, карбоновые кислоты, выделяемые микромицетами, служат источником питания для других видов микроорганизмов. Особенно существенный негативный вклад вносят ферменты микроорганизмов в процесс низкотемпературной деструкции строительных материалов.
По результатам исследований [7-10] наибольшую опасность для строительных бетонных сооружений представляют плесневые грибы р. Asspergillius и р. Penicillium (Рис. 2), которые являются наиболее активными биодеструкторами строительных конструкций.
|
|
|
||
| а) | б) | а) | б) |
| р. Asspergillius | р. Penicillium | ||
Рис. 2. Микрофотографии (а) и колонии (б) представителей плесневых грибов
р. Aspergillus и р. Penicillium
Для получения культур плесневых грибов р. Penicillium и р. Aspergillus нами использовалась готовая питательная среда Сабуро органического происхождения. Посев воздушной микрофлоры на питательную среду проводился в соответствии с общепринятой методикой культивирования микроорганизмов. На поверхности питательной среды на 3-и сутки появились видимые невооруженным глазом колонии плесневых грибов, идентифицированные как представители р. Penicillium и р. Aspergillus согласно определителю Курсанов А. И.1 (Рис. 3).
![]() |
|||
| а) | б) | в) | |
Рис. 3. Микрофлора воздуха:
а) культивирование плесневых грибов в термостате;
б) колонии плесневых грибов на 3 сутки культивирования;
в) колонии плесневых грибов на 5 сутки культивирования
Одним из наиболее перспективных и высокоэффективных способов защиты бетонных конструкций от биоразрушения, вызванного плесневыми грибами, является применение биоцидных, а именно фунгицидных, добавок. Эти химические агенты могут быть интегрированы в состав строительных материалов на стадии их производства или же введены в уже готовые бетонные конструкции посредством метода поверхностной пропитки при осуществлении ремонтно-восстановительных работ.
В качестве потенциальных противогрибковых компонентов были рассмотрены нитраты меди (II) и никеля (II). Их выбор обусловлен двумя причинами. Первая заключается в том, что соединения меди (II), активно применяемые в аграрной практике, характеризуются выраженными фунгицидными свойствами. Кроме того, хлорид никеля демонстрирует значительные антибактериальные характеристики. При этом данные соединения обладают простой структурой и высокой химической активностью, что позволяет использовать их в малых количествах. Вторая причина заключается в самопроизвольной реакции взаимодействия ИТМ с компонентами бетона, которая была термодинамически предсказана и экспериментально подтверждена, о чем говорилось выше. В таком случае, фунгицидная добавка, включенная в состав бетонной смеси, при условии сохранения эксплуатационных характеристик полученного бетона будет оказывать противогрибковое действие, с одной стороны, и, будет при этом безопасной для геосреды за счет образования труднорастворимых соединений меди (II) и никеля, с другой.
Проведенные исследования (Рис. 4) доказали наличие фунгицидной активности растворимых солей меди (II) и никеля (II) по отношению к плесневым грибам на питательной среде агар Сабуро. В чашках Петри, где среда пропитана 5% раствором нитрата меди (II) и 0,5% раствором нитрата никеля (II), развития колоний плесневых грибов на 3 сутки не наблюдается в отличие от контрольного образца. Учитывая выраженные фунгицидные свойства нитрата меди (II) и никеля (II), представляется целесообразным их интеграция в состав бетонной смеси для повышения биостойкости материала.

Рис. 4. Определение фунгицидного действия
подвижных форм меди Cu(II) и никеля Ni(II):
а) контрольный образец — дистиллированная вода;
б) 5% раствор Cu(NO3)2; в) 0,5% раствор Ni(NO3)2
Для предотвращения биокоррозии, вызванной плесневыми грибами, эффективно также применять внешнюю обработку бетонных поверхностей с использованием соединений меди и никеля. Данный подход демонстрирует высокую эффективность в ингибировании биологических процессов разрушения. Применение растворимых соединений меди и никеля обусловлено их способностью образовывать на поверхности бетона хелатные комплексы, которые блокируют метаболические пути патогенных микроорганизмов, предотвращая их размножение и деструктивную активность. Целесообразно также включать в состав средств для внешней обработки бетонных конструкций гидрофобные добавки. Эти добавки создают гидроизоляционный барьер, препятствующий проникновению влаги в структуру бетона. В результате формируются неблагоприятные условия для существования и размножения плесневых грибов, что существенно снижает или исключает риск биокоррозионных процессов.
После применения фунгицидных препаратов с гидрофобными свойствами для наружной обработки бетонных конструкций целесообразно осуществить последующее нанесение ремонтно-восстановительных композитов на поверхность. Данный подход позволит обеспечить комплексную защиту материала, повышая его устойчивость к биологическому поражению и воздействию внешних факторов окружающей среды.
Таким образом, фундаментальные свойства и индивидуальные характеристики бетонных систем приобретают первостепенное значение при решении проблемы обеспечения биостойкости строительных конструкций. Комплексное исследование этих параметров позволит разработать эффективные стратегии повышения долговечности и устойчивости бетонных сооружений к биодеструктивным процессам.
1 Курсанов А. И. Пособие по определению грибов из родов Aspergillus и Penicillium. М..: Медгиз, 1947. 116 с.
1. Svatovskaya L. B. et al. Application of engineering and chemical knowledge in geo-ecological protection construction technologies (including nanotechnology): monograph. / L. B. Svatovskaya, A. M. Sycheva, A. V. Khitrov, M. V. Shershneva, M. M. Baidarashvili, A. S. SakharovaSt. Petersburg : St. Petersburg State University of Railway Transport, 2013. 80 p. EDN: https://elibrary.ru/SQJLIH
2. Svatovskaya L. B. Mineral geoantidotes for detoxification of the lithosphere // New research in materials science and ecology: collection of scientific papers. St. Petersburg : St. Petersburg State University of Railway Transport, 2012. pp. 3-12.
3. Svatovskaya L. B., Shershneva M. V., Sycheva A.M., Makarova E. I. Engineering and chemical foundations of forecasting geoprotective properties solids and new technologies of neutralization. St. Petersburg : St. Petersburg State University of Railway Transport, 2010. EDN: https://elibrary.ru/QMGVFT
4. Svatovskaya L. B., Maslennikova L. L., Makarova E. I., Shershneva M. V., Babak N. A. Engineering, chemical and natural science foundations of the creation of new eco- and geo-protective technologies. St. Petersburg : St. Petersburg State University of Railway Transport. 2011. – 88 p. EDN: https://elibrary.ru/QNFEQZ
5. Svatovskaya L.B. Some problems of modern geoecology and ways to solve them // New research in materials science and ecology: collection of scientific papers, Issue 7. St. Petersburg : St. Petersburg State University of Railway Transport, 2007. pp. 3-4
6. Shapovalov I.V. Bio–damage of building materials by mold fungi. Abstract of the dissertation for the degree of Candidate of Technical Sciences – Belgorod, BSTU, 2003. p. 17. EDN: https://elibrary.ru/NMLSQJ
7. Solovyova, V. Ya., Stepanova I. V. Biological corrosion of concrete // Geoecochemistry of lithosphere protection : Proceedings of the IX International Scientific and Practical Internet Conference, Moscow, June 01-02, 2023. Moscow: Sputnik+, 2023. pp. 8-11. EDN: https://elibrary.ru/VOFZQG
8. Parfenova L. M., Vishnyakova Yu. V., Shauro A. A. Bio–resistance of modified cement stone to mold fungi // Bulletin of Polotsk State University, 2017. № 8, pp. 58-62.
9. Uryasheva N. N. Interaction of microorganisms with stone building materials // Bulletin of SUSU. Series "Construction and Architecture", 2017. Vol. 17, № 3. pp. 65-71 DOI: https://doi.org/10.14529/build170310; EDN: https://elibrary.ru/ZEZDIT
10. Stroganov V.F., Sagadeev E.V., Kukoleva D.A. A comprehensive study of the processes of bio-damage of mineral building materials // News of the Kazan State University of Architecture and Engineering. 2011. № 4 (18). Pp. 274-281.